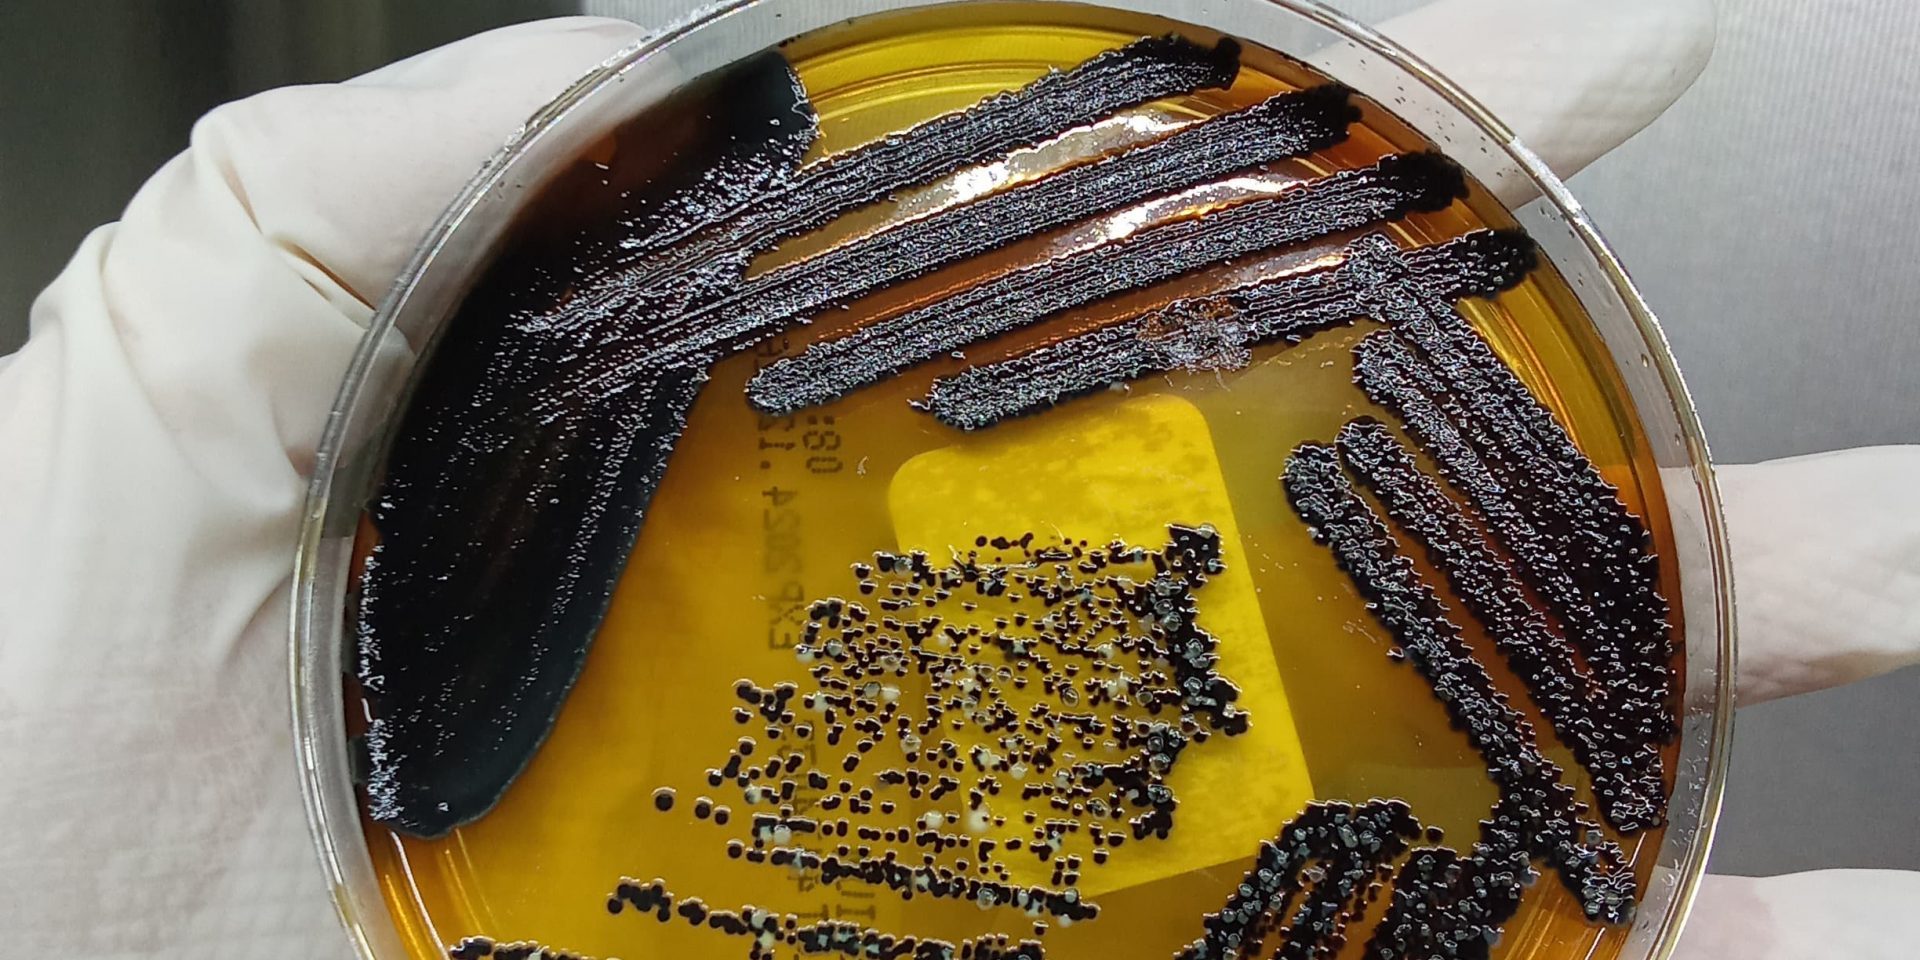

La diarrea, fiebre, falta de apetito, deshidratación, pérdida de peso e incluso la muerte súbita en casos de infecciones agudas son algunos de los síntomas más característicos de la Salmonella en conejos.
Esta infección bacteriana puede desarrollarse con mayor frecuencia en situaciones de estrés, mala higiene o cuando el sistema inmunitario del animal está debilitado.
Por ello, realizar un cultivo bacteriano es fundamental para detectar de forma eficaz la presencia de Salmonella. Además, gracias al antibiograma, podemos identificar el tratamiento antibiótico más adecuado para combatir la infección.
Este enfoque no solo garantiza un tratamiento efectivo, sino que también permite resolver el problema de la manera más rápida posible, mejorando así la salud y bienestar del animal.